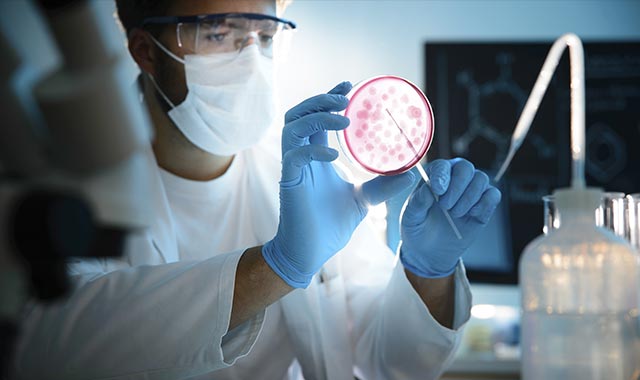

The global Biodefense Market is estimated to be valued at US$ 13.4 Bn in 2023 and is expected to exhibit a CAGR of 4.8% over the forecast period 2023 to 2030, as highlighted in a new report published by Coherent Market Insights.
Market Overview:
Biodefense involves protecting people and society from deliberate attacks using biological agents such as viruses, bacteria, toxins, or other biological substances. Biodefense products include vaccines, monoclonal antibodies, recombinant proteins, small-molecule antibiotics, antivirals and others. These products help the body develop immunity to dangerous pathogens that can potentially cause disease. With increasing global threats of bioterrorism and pandemics, biodefense has become crucial for national security. Governments worldwide are increasing their spending on biodefense research, stockpiling treatments and forming strategic collaborations.
Market key trends:
One of the key trends in the biodefense market is the development of broad-spectrum antimicrobials and antivirals. With new infectious diseases emerging frequently, there is a need for therapeutic agents that are effective against multiple pathogens. Companies are conducting extensive research to develop broad-spectrum drugs, vaccines and monoclonal antibodies that provide immunity or treatment against a wide range of threat agents. Another notable trend is the growing collaboration between government organizations and private players. Government biodefense programs are partnering with pharmaceutical companies and research institutes to fast-track the development and stockpiling of medical countermeasures. Such partnerships help enhance preparedness by leveraging the skills and resources of each sector. Furthermore, increasing R&D investment in pandemic prevention technologies is a major trend. This includes development of rapid point-of-care diagnostic tests, new generation of vaccines and telehealth solutions to address healthcare needs during outbreaks.
Porter’s Analysis
Threat of new entrants: The threat of new entrants is moderate in the biodefense market due to high capital requirement for R&D and manufacturing facilities. New companies also need to invest in product approvals which makes entry difficult.
Bargaining power of buyers: The bargaining power of buyers is low in this market as the products have limited substitutes and are essential for defense against biological threats. Buyers have less influence on pricing.
Bargaining power of suppliers: The bargaining power of suppliers is moderate as they supply inputs for biodefense products like fill-finish solutions, bulk pharmaceutical ingredients etc. Suppliers have some influence in influencing pricing.
Threat of new substitutes: The threat of new substitutes is low in this industry as the products have unique life-saving applications against biological threats. New substitutes are difficult to develop and get regulatory approvals.
Competitive rivalry: The competitive rivalry is high among the key players to gain more market share and develop new products in this market.
Key Takeaways
The Global Biodefense Market Size is expected to witness high growth, exhibiting a CAGR of 4.8% over the forecast period of 2023 to 2030, due to increasing government funding and innovation. The total market size for biodefense in 2023 is estimated to be US$ 13.4 Bn.
Regional analysis: North America dominates the global biodefense market owing to increasing R&D investment and presence of key players in the US. Asia Pacific is expected to grow at the fastest pace during the forecast period due to rising defense budgets.
Key players: Key players operating in the biodefense market are Emergent Biosolutions Inc., SIGA Technologies Inc., Bavarian Nordic A/S, Elusys Therapeutics Inc., and Ichor Medical Systems Inc. These players are focusing on partnerships, M&As and new product launches to strengthen their market position.
*Note:
1. Source: Coherent Market Insights, Public sources, Desk research
2. We have leveraged AI tools to mine information and compile it